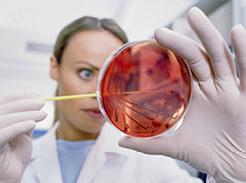
Ασφαλέστερο το τεστ HPV από το τεστ Παπ στην διάγνωση του καρκίνου του τραχήλου της μήτρας

Παρών στο 50% των τεστ Παπ ο ιός HPV – Σημαντικός ο εμβολιασμός
Επιδημία θα μπορούσε να χαρακτηριστεί η λοίμωξη από τον ιό των ανθρώπινων θηλωμάτων (HPV) καθώς στο 50% των τεστ Παπανικολάου υποδηλώνεται η παρουσία του. Ο ιός HPV έχει αποδειχθεί ότι εκτός από τον καρκίνο του τραχήλου της μήτρας και τις προκαρκινικές τραχηλικές αλλοιώσεις, σχετίζεται, μεταξύ άλλων, με καρκίνο και προκαρκινικές αλοιώσεις στον πρωκτό, τον κόλπο και το αιδοίο.

Αριθμός Πιστοποίησης Μ.Η.Τ.232442
Αριθμός Πιστοποίησης Μ.Η.Τ.232442